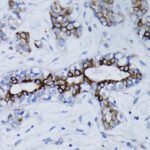
BRCA1 Rabbit pAb

BRCA1 Rabbit pAb
application (WB, ELISA) & cross reactivity (Human, Mouse)
$239.89 Commercial Only
Authorities in our business will tell in no uncertain terms that Lorem Ipsum is that huge, huge no no to forswear forever. Not so fast, I'd say, there are some redeeming factors in favor of greeking text, as its use is merely the symptom of a worse problem to take into consideration.
Product details
application (WB, ELISA) & cross reactivity (Human, Mouse)
| Brand | ABclonal Technology |
|---|---|
| Manufacturer | ABclonal Technology |
| Product Size | 100ul |
| Size / Quantity | 1-EA |
Description
Size quantity: 1-EA Description: This gene encodes a 190 kD nuclear phosphoprotein that plays a role in maintaining genomic stability, and it also acts as a tumor suppressor. The BRCA1 gene contains 22 exons spanning about 110 kb of DNA. The encoded protein combines with other tumor suppressors, DNA damage sensors, and signal transducers to form a large multi-subunit protein complex known as the BRCA1-associated genome surveillance complex (BASC). This gene product associates with RNA polymerase II, and through the C-terminal domain, also interacts with histone deacetylase complexes. This protein thus plays a role in transcription, DNA repair of double-stranded breaks, and recombination. Mutations in this gene are responsible for approximately 40% of inherited breast cancers and more than 80% of inherited breast and ovarian cancers. Alternative splicing plays a role in modulating the subcellular localization and physiological function of this gene. Many alternatively spliced transcript variants, some of which are disease-associated mutations, have been described for this gene, but the full-length natures of only some of these variants has been described. A related pseudogene, which is also located on chromosome 17, has been identified.